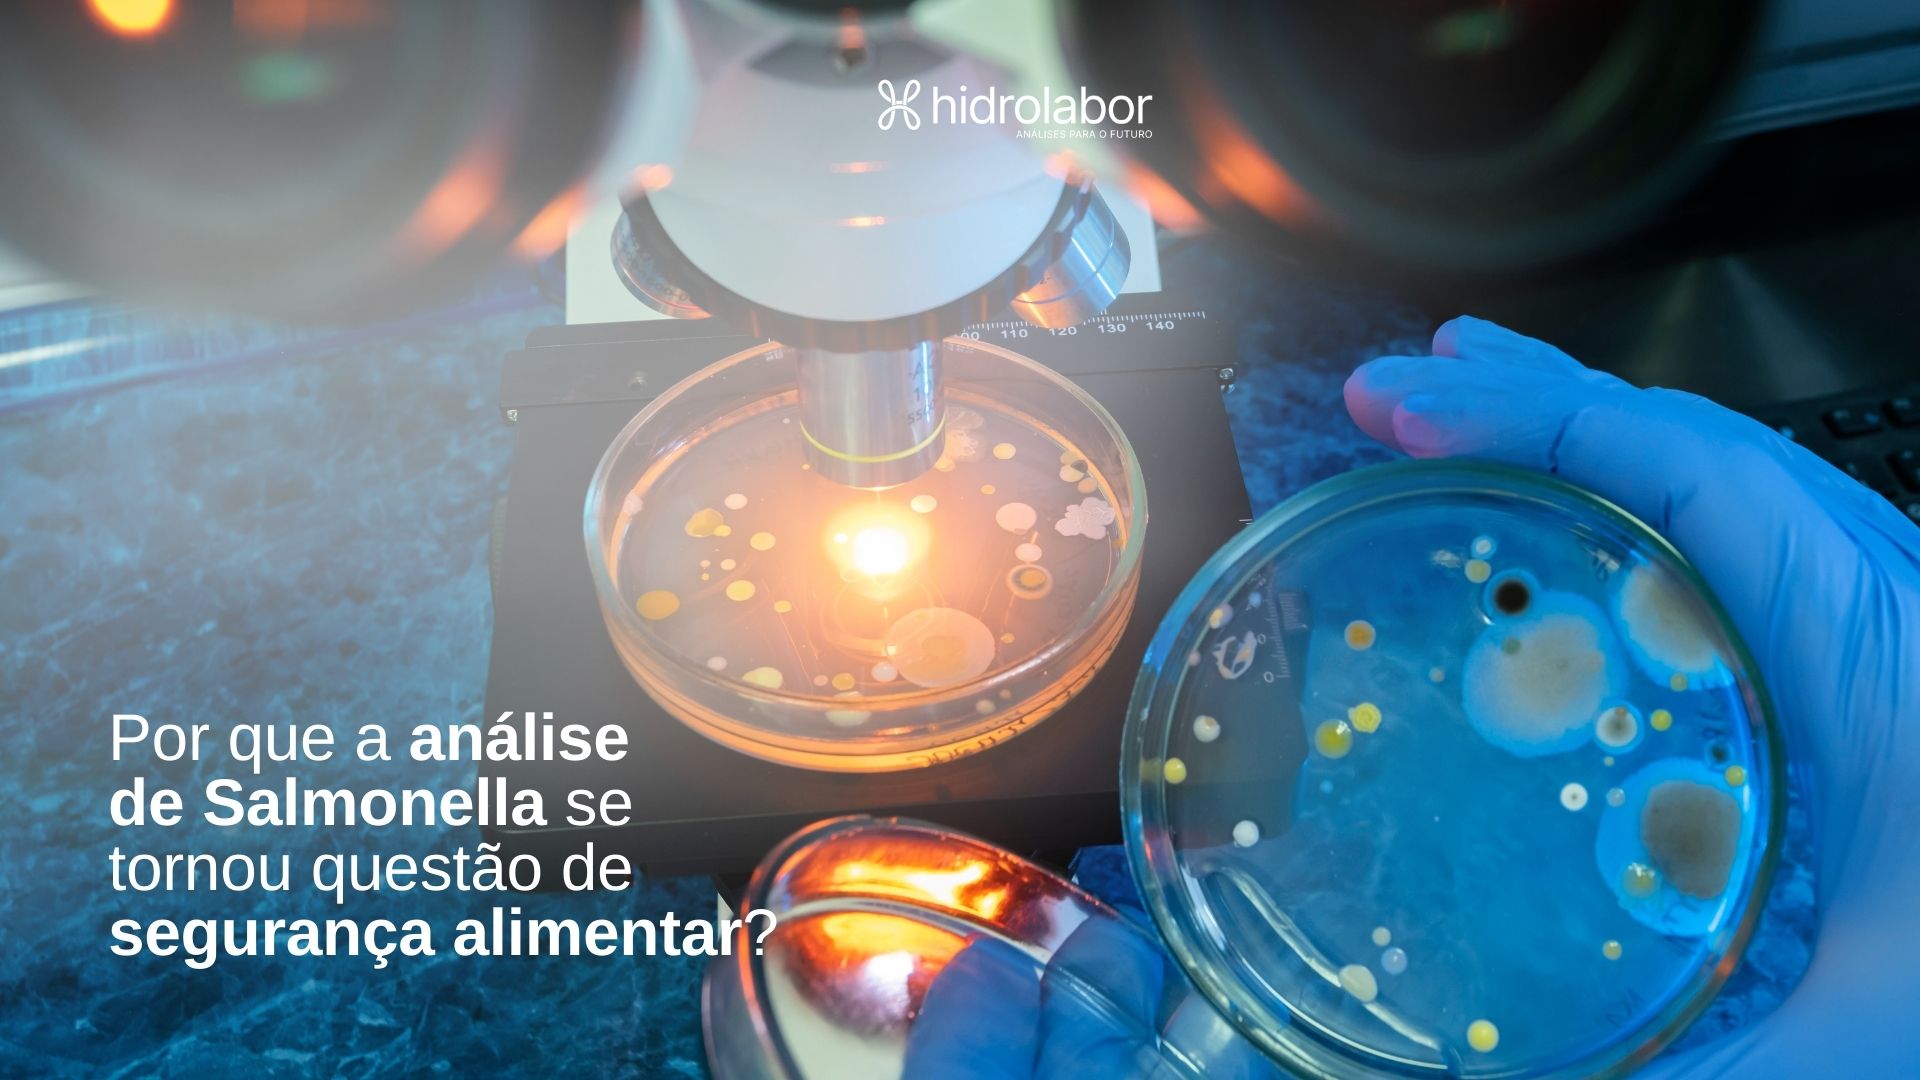
Por que a análise de Salmonella se tornou questão de segurança alimentar?

Confira nosso Blog
e as últimas notícias

26.05.12

25.10.06
Análise da água: o que diz a legislação e como garantir qualidade e segurança no consumo
Leia mais +
25.09.29
A contaminação silenciosa que ameaça a segurança alimentar de comunidades tradicionais em zona rural do Ceará
Leia mais +
25.09.22
Tudo o que sua empresa precisa saber sobre tabela nutricional e rotulagem obrigatória
Leia mais +







25.01.16
A importância da análise de agrotóxicos para controle da poluição e segurança alimentar
Leia mais +

24.12.01
Congelou, descongelou e agora? Saiba como manter a segurança alimentar na sua casa
Leia mais +














24.06.06
Atualização do escopo de acreditação: avanços no monitoramento ambiental e de alimentos
Leia mais +
